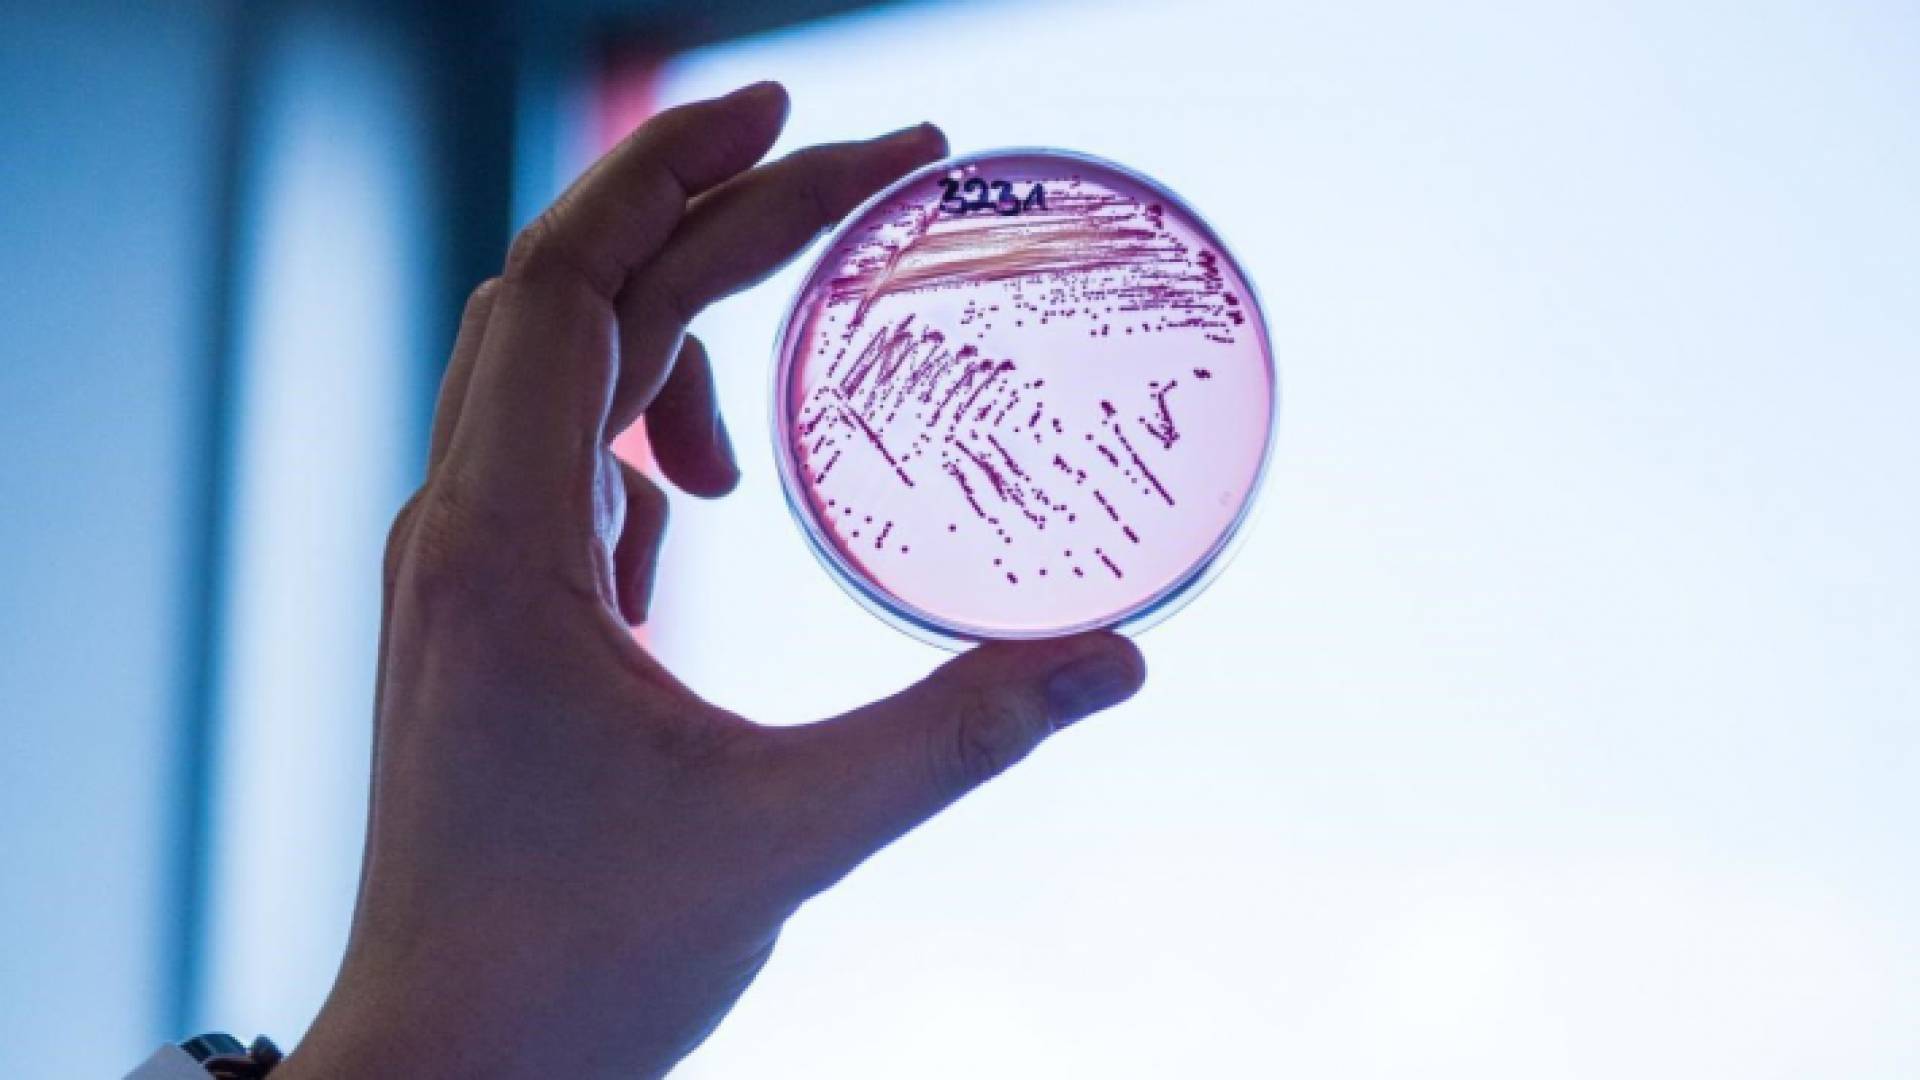
مختبرات طبية

مختبرات طبية
"الغذاء والدواء" تعلن نتائج عينات حالات التسمم في جرش والمفرق
- النتائج أظهرت تلوث عينات المثومة والصلصة الحارة ببكتيريا السالمونيلا
- المطعم هو مصدرالوجبات المرتبطة بحالات التسمم
كشفت المؤسسة العامة للغذاء والدواء عن النتائج الأولية للتحليل المخبري للعينات المرتبطة وبائيا بحالات التسمم الغذائي في محافظتي جرش والمفرق أظهرت تلوث عينات الدجاج المطبوخ والنيئة بالبكتيريا الممرضة كامبيلوباكتر (Campylobacter spp ) و بكتيريا السالمونيلا (Salmonella spp )والتي يشير وجودها إلى عدم التزام القائمين على تحضيرها بالاشتراطات والممارسات الصحية الجيدة.
وأظهرت النتائج الأولية أظهرت تلوث عينات المثومة والصلصة الحارة ببكتيريا السالمونيلا الممرضة Salmonella spp والتي يعتبر وجودها خطرا على صحة المستهلك حسب التعليمات الميكروبية للأغذية الجاهزة للأكل لعام 2011 الصادرة عن المؤسسة العامة للغذاء والدواء ، بحسب بيان صادر عن المؤسسة العامة للغذاء والدواء .
كما اظهرت النتائج أنه عند الكشف الميداني من قبل فرق التفتيش التابعة للمؤسسة تبين عدم الالتزام بالممارسات الصحية الجيدة خلال عملية التحضير والتجهيز والطهي واستخدام مواد أولية تدخل في الوجبة من مصادر غير مأمونة.
فضلا عن ذلك فقد تبين أيضا أن إعداد الوجبات بصورة سريعة غير كافية لانضاج واستواء مادة الدجاج بشكل يمنع وجود البكتيريا في الوجبة المقدمة للمستهلك.
كما تبين اثناء الكشف حدوث تلوث متبادل (cross contamination ) ما بين المادة الحاملة للبكتيريا والمواد الغذائية الأخرى مثل المثومة والصلصة الحارة.
وأشارت المؤسسة إلى أن المطعم هو مصدرالوجبات المرتبطة بحالات التسمم وقد شهد إقبالا كبيرا خلال عطلة نهاية الاسبوع الماضية من قبل المواطنين حسب المصابين.
واضافت المؤسسة أن أعراض التسمم تحتاج لفترة حضانة تتراوح من 24 ساعة وحتى 48 ساعة من تناول الطعام الملوث وهو ما تم رصده.
الإجراءات الأصولية المتبعة
كما تأكدت فرق التفتيش والرقابة التابعة للمؤسسة اثناء الكشف من حصول العاملين في المطعم والمشغل على الشهادات الصحية الصادرة عن وزارة الصحة ضمن الاجراءات الاصولية المتبعة.
وشددت المؤسسة على أن فرق الرقابة والتفتيش التابعة للمؤسسة توجهت فور ورود معلومات تتعلق بحالات تسمم غذائي في جرش للكشف على المنشأة الغذائية المرتبطة بحالات الاشتباه بالتسمم واتخذت كافة الإجراءات الاحترازية اللازمة حسب البروتوكول المعتمد للتعامل مع فاشيات الأمراض المنقولة بالغذاء والتي شملت:
- إغلاق المطعم وكافة فروعه.
- إغلاق المشغل الرئيسي الموزع لكافة الفروع التابعة للمطعم بعد فحص وتقييم المواد الأولية المستخدمة في تجهيز الوجبات.
- سحب عينات موسعة من المواد الغذائيه المتداولة هناك وكذلك من الوجبات المعدة ومدخلات انتاجها لغايات تحليلها مخبريا في مختبرات المؤسسة.
يشار إلى ان عدد الحالات المشتبه بإصابتها بالتسمم في جرش ارتفع إلى 120 حالة، بينهم طفلان، وفق ما ذكر مراسل "رؤيا".